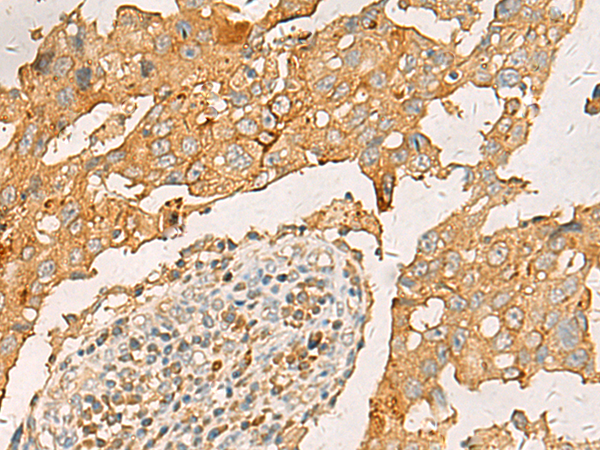

-
分类: 科研抗体货号: P12688别名: LNCR2应用: WB,IHC反应种属: Human, Mouse, Rat
-
分类: 科研抗体货号: P12657别名: HYA1; PH20; HYAL1; HYAL3; HYAL5; PH-20; SPAG15; HEL-S-96n应用: IHC反应种属: Human
-
分类: 科研抗体货号: P12705别名: D4; GDIA2; GDID4; LYGDI; Ly-GDI; RAP1GN1; RhoGDI2应用: WB,IHC反应种属: Human, Mouse
-
分类: 科研抗体货号: P12686别名: KG19; BNAS1; HCCR-1; HCCR-2; HCCRBP-1应用: WB,IHC反应种属: Human, Mouse
-
分类: 科研抗体货号: P12656别名: B99应用: IHC反应种属: Human, Mouse
-
分类: 科研抗体货号: P12704别名: D-DT; DDCT; MIF2; MIF-2应用: WB,IHC反应种属: Human
-
分类: 科研抗体货号: P12682别名: HSPG; CD362; HSPG1; SYND2应用: IHC反应种属: Human, Mouse, Rat
-
分类: 科研抗体货号: P12654别名: FSP; GRO1; GROa; MGSA; NAP-3; SCYB1; MGSA-a应用: IHC反应种属: Human, Mouse, Rat
-
分类: 科研抗体货号: P12702别名: D40; CT29; Spc7; CASC5; MCPH4; hKNL-1; AF15Q14; PPP1R55; hSpc105应用: IHC反应种属: Human
-
分类: 科研抗体货号: P12680别名: HSP84; HSPC2; HSPCB; D6S182; HSP90B应用: IHC反应种属: Human, Mouse, Rat

鄂公网安备42018502007531号
鄂公网安备42018502007531号

